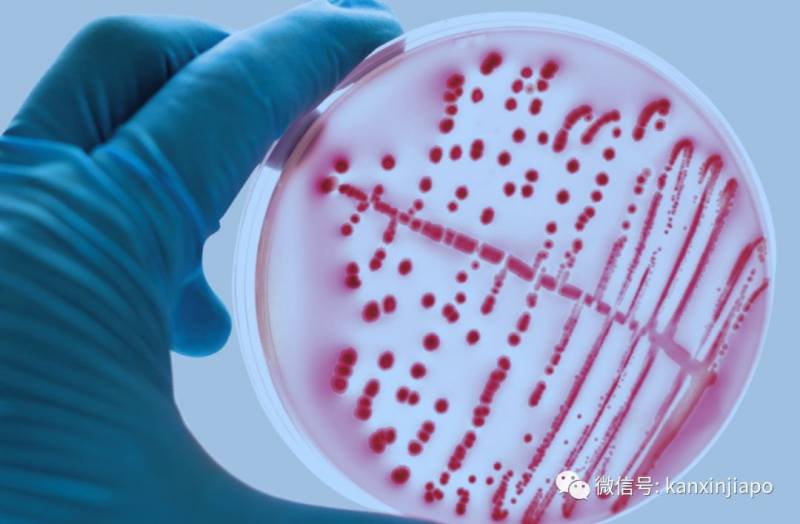

新加坡最新确诊的新型肺炎病例,怎么没去医院
截至(1月28日)下午,新加坡共确诊7起新型冠状病毒肺炎病例。确诊的第5例及第7例患者均被紧急送往新加坡国家传染病中心隔离检查,这个声明不显的中心究竟是什么来头?如何能接收来自陈笃生医院等知名医院转出的棘手病患? 新加坡国家传染病中心(National Centre for Infectious Diseases,简称NCID)是在2018年才开始投入运作的,替代了原有的新加坡传染病中心。这是个什么地方?为什么会被送到这里?新加坡国家传染病中心(National Centre for Infectious Diseases,简称NCID)是在2018年才开始投入运作的,替代了原有的新加坡传染病中心。

多了一个“国家”(National),职能也更加广泛了。除了原有的传染病的临床治疗和暴发管理外,NCID的新职能部门还包括国家公共卫生和流行病学部门,国家公共卫生实验室,传染病研究与培训办公室, 抗菌素耐药性协调办公室以及针对艾滋病毒和肺结核的国家公共卫生计划。通俗点讲,这是一个更加偏重传染病科研的机构。

2019年1月起,NCID的公共卫生和临床实验室、大型检测中心、手术室、重症监护室和隔离病房开始逐一投入使用。为了增强新加坡在传染病管理和预防方面的能力,NCID总共设有330个床位的专用设施,可在疫情暴发时容纳近500个床位。

NCID的住院设施共计17个病房,330张床,其中包括:•1个配有4个高级别隔离装置和8个负压床的高级别隔离病房•5个配备100个床的负压病房•5个隔离病房,配备100张床•4个队列病房,配备80张病床,包括16张负压病床•2个ICU重症病房,配备38张床其他临床设施和服务:•门诊•放映中心•2间手术室•卫星诊断实验室•药学公共卫生设施:•生物安全2和3级参考实验室•研究实验室•研究病房•研究诊所•结核病安全设施•NCID护理与此同时,五楼设有新加坡首个高度隔离病房,病房内还设有生物封存病房,为了专门针对治疗像埃博拉(Ebola)、SARS、猴痘等具有高传染性、高死亡率的疑似或确诊病例。敲黑板,划重点,这里有非常稀少的“高度隔离病房”......
NCID位于诺维娜健康城市的心脏地带,与陈笃生医院,李光前医学院和吴腾芳医疗创新中心紧密相连,在疫情突发时,能实现跨机构协作和协调的运营。National Centre for Infectious Diseases(国家传染病中心)地址:16 Jalan Tan Tock Seng,Singapore 308442
评论